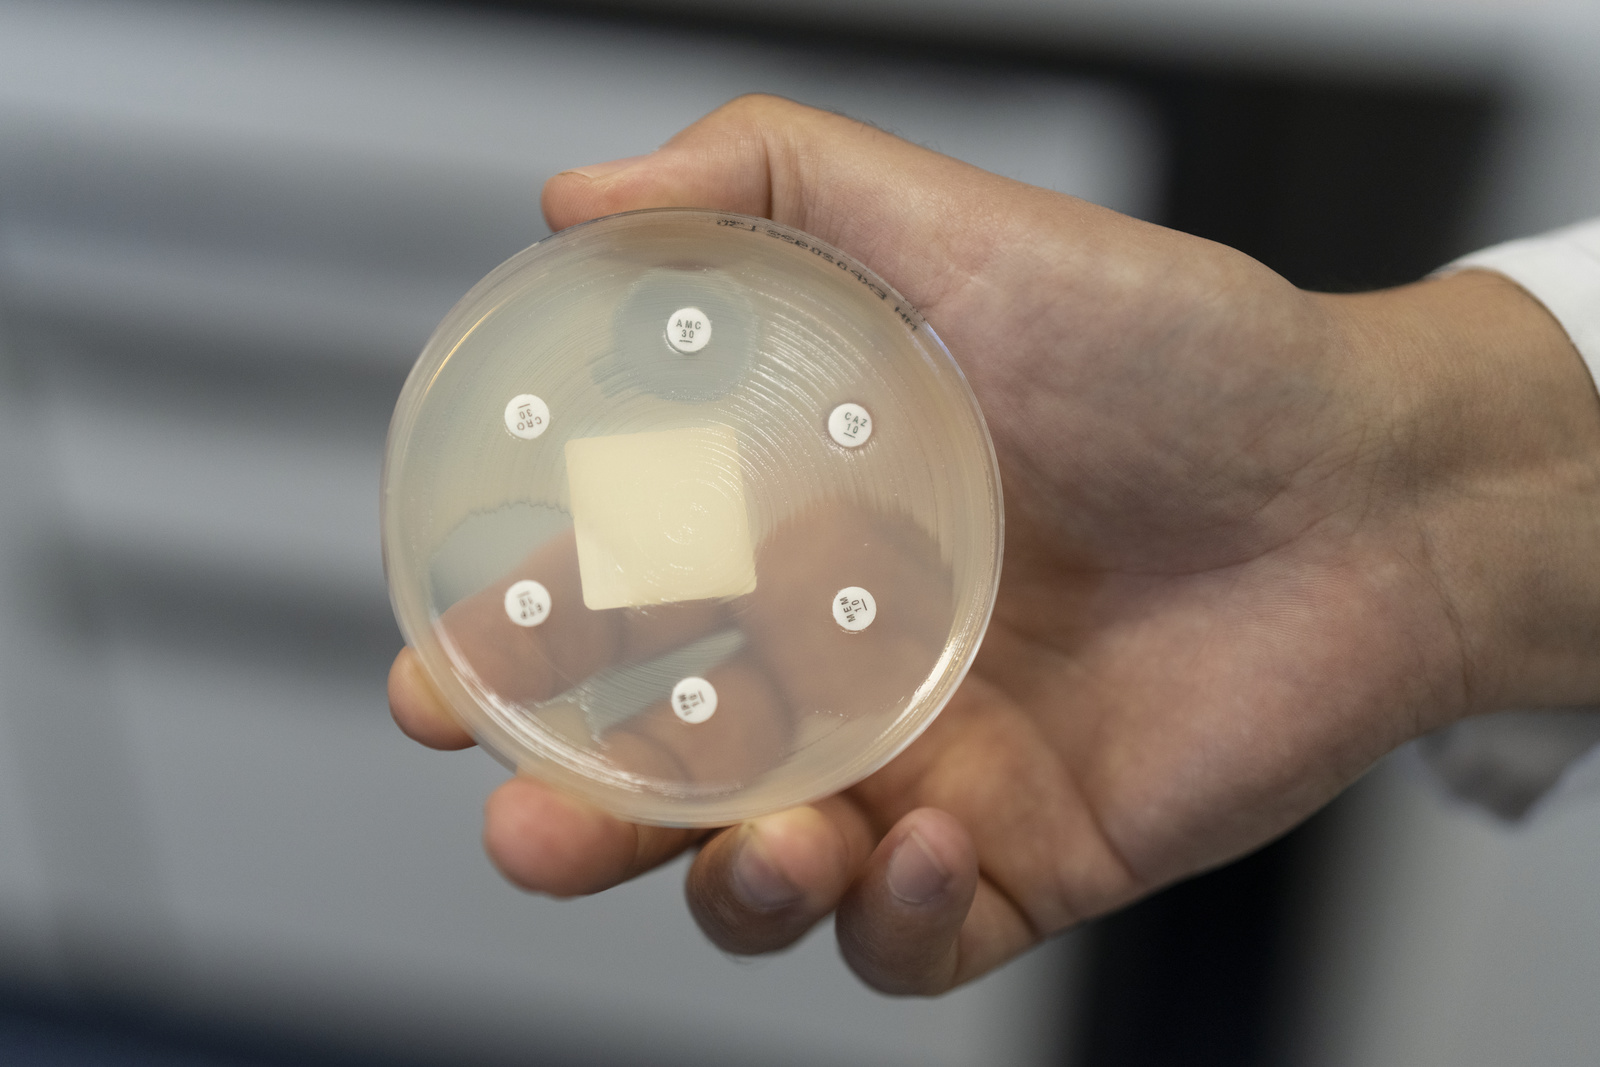

C’est une première suisse et ça se passe à Genève. Un patient des HUG souffrant d’une infection bactérienne pulmonaire chronique résistante aux antibiotiques a pu être sauvé grâce aux bactériophages. Ces résultats sont à découvrir ce mardi dans la revue Nature Communications.
Le traitement a été réalisé avec succès par une équipe multidisciplinaire des Hôpitaux universitaires de Genève et de l’Université de Genève.
Le patient âgé de 41 ans souffrait d’une atteinte pulmonaire chronique avec une souche multirésistante de la bactérie Pseudomonas aeruginosa. Au bout de six mois d'hospitalisation aux HUG et totalement dépendant d’une antibiothérapie intraveineuse en continu, aucune amélioration n’est constatée. Le patient va finalement recevoir un traitement expérimental de dernière chance par phages autorisé à titre compassionnel. Traitement qui va le sauver, puisque cet homme a quitté l’hôpital depuis, il a pu retrouver son autonomie et reprendre son travail. C'est ce que nous explique le professeur Christian Van Delden, médecin adjoint agrégé au Service des maladies infectieuses des HUG et professeur ordinaire au Département de médecine de la Faculté de médecine de l’UNIGE.
Stratégie prometteuse pour lutter contre la résistance aux antibiotiques
La phagothérapie permet de tuer les bactéries multirésistantes en utilisant un phage, un virus qui est l'ennemi naturel de la bactérie. Utilisés en combinaison avec des antibiotiques, ces phages contournent la résistance aux antibiotiques.
Même si cette stratégie est prometteuse, des données fondamentales scientifiques et cliniques sont encore nécessaires pour développer des traitements efficaces, sans danger et approuvés par les autorités sanitaires, ce qui n’est pas encore le cas aujourd’hui.
Approche thérapeutique personnalisée
Les bactéries peuvent développer des résistances aux phages comme aux antibiotiques. Pour augmenter les chances de succès thérapeutique, les chercheurs devaient donc trouver et sélectionner le phage approprié pour la souche bactérienne infectant spécifiquement le patient avant la phagothérapie. Pour ce faire, l’équipe des HUG et de l’UNIGE a d’abord isolé les bactéries des sécrétions respiratoires du patient, puis a déterminé le type de bactéries présentes, leur profil génétique et leur résistance tant aux antibiotiques qu’à une banque de phages. Une recherche intense, les HUG vont chercher dans leur banque de phages, celle du CHUV mais également du Centre européen de phages de l’Hôpital militaire Reine Astride à Bruxelles,. Des centaines de phages différents sont étudiés, en vain. C'est finalement à l’Université de Yale aux États-Unis que le phage actif sur les bactéries du patient est identifié.
Aucun effet secondaire
Les phages ont été administrés par aérosols tout en maintenant les antibiotiques intraveineux. L’amélioration du patient a été spectaculaire et ceci sans aucun effet secondaire. « Toutefois, il est important de souligner que la phagothérapie est utilisée en complément de l’antibiothérapie et non en remplacement », insiste le Pr Christian van Delden, avant de souligner l’importance de la recherche de nouvelles stratégies pour lutter contre l’antibiorésistance. L’équipe genevoise salue aussi la collaboration avec le groupe américain qui a généreusement fourni les phages sans contrepartie. Christian van Delden le confirme : « sans eux, cette vie n’aurait pas pu être sauvée ».
Prochain objectif: que Swissmedic autorise une utilisation plus large de ces phages pour les expérimenter sur des infections résistantes aux antibiotiques comme les cystites.
José-Maria, le fameux patient de 41 ans, a accepté de témoigner. Il salue l'équipe multidisciplinaire qui "lui a sauvé la vie".